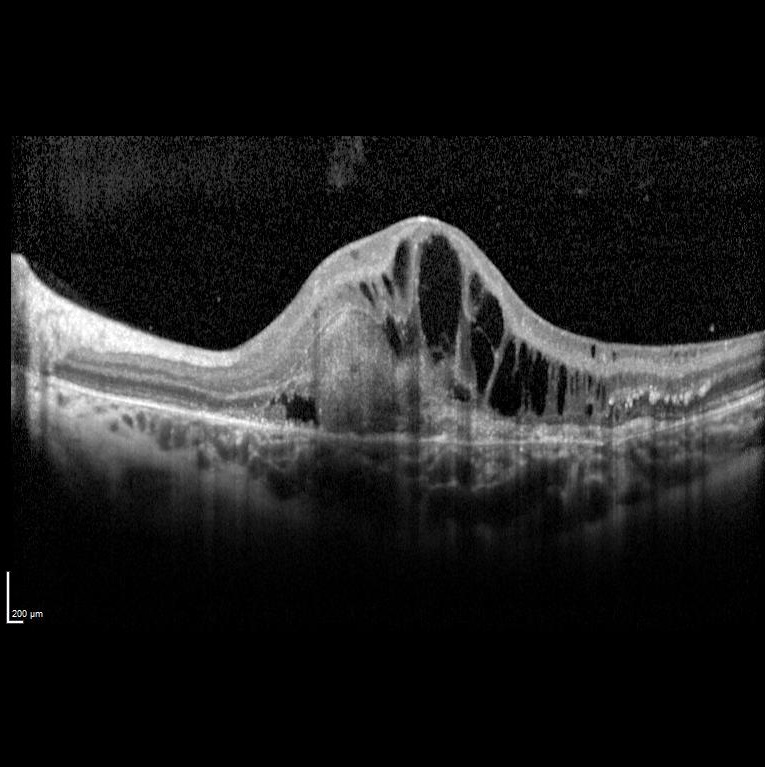

2026 Mart Ayın Sorusu
Okuma:532
2026 Mart Ayın Sorusu
Sol gözde bir haftadır görme azlığı şikayeti başlayan ve görme keskinliği 5 mps düzeyinde olan 15 yaşındaki kadın hasta retina kliniğimize refere edilmiştir. Hastanın renkli fundus ve optik koherens tomografi görüntülerini görmektesiniz. Hastanın doğumunda bir enfeksiyon öyküsü vardır. Sistemik bir hastalığı yoktur. Bu bulgulara göre tanınız nedir? Lütfen cevabınızı aşağıya yazınız.
Ayın sorusunu bizimle paylaşan Dr. Mehmet Yasin TEKE’ye katkıları için teşekkür ederiz.
2026 Ocak Ayın Sorusu Cevap
Bu ay size sol gözde bir haftadır görme azlığı şikayeti başlayan ve görme keskinliği 5 mps seviyesinde olan 15 yaşındaki kadın hastanın renkli fundus ve optik koherens tomografi görüntüleri eşliğinde tanısını sormuştuk.
Tanı: Rubella Retinopati ve maküla/koroid neovaskülarizasyonu’dur.
Konjenital rubella vakaları genellikle katarakt, mikroftalmi, glokom veya pigmenter retinopati ile oftalmoloji bölümüne başvurur. Görme kaybı genellikle katarakt veya eşlik eden mikroftalmi ve nistagmus nedeniyle olur. Pigmenter retinopati tek başına genellikle görme kaybına yol açmaz. Makuladaki retinal tabakaların kronik atrofisine bağlı pigmenter retinopati ile ilişkili olarak gelişen maküla/koroid neovaskülarizasyonu görme kaybına yol açar.
Literatürde rubella retinopatisine bağlı maküla/koroid neovaskülarizasyonu hakkında az sayıda rapor bulunmaktadır. Çalışmalar, kızamıkçık retinopatisine bağlı maküla/koroid neovaskülarizasyonunun yedavi edilmez ise tipik olarak kötü bir görsel prognoza sahip olduğunu göstermiştir. Birkaç istisna dışında, hastalarda diskiform skarlaşma gelişmiş ve görme keskinliği önemli ölçüde azalmıştır.
Literatürde fotodinamik tedavi (PDT) ve anti-VEGF ajanları gibi birkaç tedavi seçeneği tanımlanmıştır. PDT'nin etkili bir tedavi seçeneği olduğu ve neovasküler membranın involüsyonuna, subretinal kanamanın çözülmesine ve görme keskinliğinde iyileşmeye yol açtığı bulunmuştur. Anti-VEGF tedavisi, başka bir seçenektir. Yaygın olarak kullanılan anti-VEGF ajanları bevacizumab, ranibizumab ve aflibercepttir. Anti-VEGF ile maküla/koroid neovaskülarizasyonu'nun önemli ölçüde düzeldiği rapor edilmiştir. Olgumuzda da bu durum izlenmiştir.
Ayın sorusuna web sitesi aracılığıyla doğru cevap verenler arasında yapılan kura çekimi sonrası kitap ödülünü Sn. Dr. Ömer Şahin kazanmıştır. Kendilerini tebrik ederiz.
Kitap ödülünün temin ve dağıtımında koşulsuz destekleri için DEVA Holding’e teşekkür ederiz.